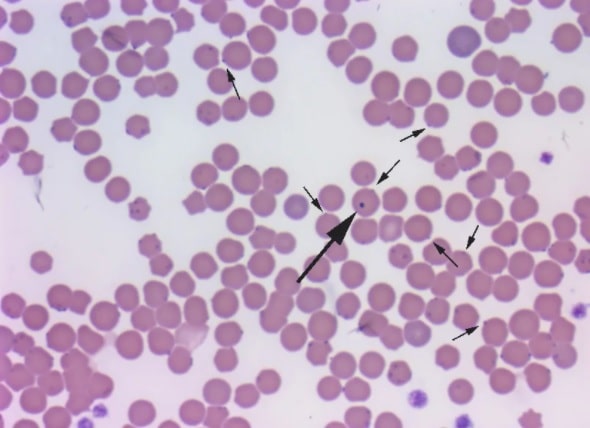
Мікоплазмоз у собак: що це?

Зміст статті
Мікоплазмоз у собак — інфекція, що провокується одноклітинними мікроорганізмами сімейства мікоплазми. Після зараження патогени можуть тривалий період ніяк себе не проявляти. Інфекція стрімко розвивається, якщо тварина сильно ослаблена. Своєчасно проведені діагностика на тлі симптомів і лікування допоможуть уникнути серйозних проблем зі здоров’ям вихованця.
Мікоплазмоз у собак: що це?
Мікоплазменна інфекція у собак — захворювання, що викликається переважно мікроорганізмами роду Mycoplasma cynos. Патоген паразитує на слизових оболонках органів зору, дихання, шлунково-кишкового та сечостатевого тракту. Живляться мікоплазми за рахунок клітин епітелію, до яких прикріплюються.
Під час життєдіяльності мембранні паразити виділяють аміак і перекис водню, що порушують нормальне функціонування уражених тканин.
При міцному імунітеті та відсутності хронічних патологій, мікоплазмоз протікає в латентній (прихованій) формі. У цуценят, літніх і ослаблених особин інфекція, залежно від локалізації патогена, проявляється кон’юнктивітом, захворюваннями сечостатевої, дихальної системи, шлунково-кишкового тракту та опорно-рухового апарату.
Мікоплазми мешкають в організмі більшості здорових собак. Захворювання мембранні патогени спричиняють тільки у 10-15% інфікованих тварин.
Чи передається людині мікоплазмоз собак?
Mycoplasma cynos не є небезпечною для людей. Цей вид патогена паразитує тільки на представниках псових. Незважаючи на це, під час контакту з хворим собакою слід дотримуватися правил особистої гігієни. Після кожного спілкування з вихованців необхідно мити руки з милом. При догляді за хворою твариною, краще використовувати гумові рукавички.
Шляхи зараження
Основними переносниками захворювання в навколишньому середовищі є миші та щури. Гризуни є носіями мікоплазм і здатні заразити собак повітряно-крапельним, контактним шляхом, через заражений корм.
Інфекція також може передаватися в процесі в’язки пса і суки, якщо одна з тварин заражена. Цуценятам мікоплазмоз часто передається родовим шляхом. Також можливе внутрішньоутробне зараження, що стає причиною смерті плода.
У інфікованих собак із міцним імунітетом мікоплазмоз протікає безсимптомно. Вони є носіями, виділяють збудника в навколишнє середовище і є потенційно небезпечними для інших тварин.
Симптоми хвороби
Симптоматика мікоплазмозу залежить від локалізації мембранного паразита. Найчастіше патоген вражає слизову оболонку очей, що призводить до розвитку кон’юнктивіту. Запалення кон’юнктиви може бути як одностороннім, так і двостороннім. Супроводжується сльозотечею, набряком повік, серозними або гнійними виділеннями.
Мікоплазми, що осіли в органах дихання, призводять до розвитку ринітів, бронхіту, пневмонії. Часто захворювання поєднується з аденовірозом у собак. При ураженні дихальної системи у тварини спостерігаються нежить, чхання, кашель.
Нерідко мікоплазмоз у собак вражає слизові пащі, призводячи до розвитку гінгівіту, супроводжуваного запаленням, кровотечею ясен.
При розвитку інфекції в урогенітальних шляхах у сук спостерігаються вагініти, у псів — баланопостити, простатити. Для статевих хвороб характерні виділення різного характеру з вульви або уретри.
Мікоплазмоз, що протікає в сечовидільних органах, проявляється уретритом, пієлонефритом або циститом у собак. Перші симптоми інфекцій сечовидільної системи — часті та мізерні позиви до сечовипускання, неспокійна поведінка вихованця.
Патогени, що оселилися на шкірі, спричиняють сверблячі дерматози, що мають різний ступінь вираженості.
Обережно! Нижче, неприємний контент!
Це фото містить матеріали, які можуть здатися людям неприємними.
Фото прояву мікоплазмозу при ураженні ока (запалення кон’юнктиви на тлі мікоплазмозу у собаки): посилання на фото. Чутливий контент.
При ураженні суглобів спостерігаються симптоми артриту: собака кульгає (частіше на одну лапу), відмовляється наступати на уражену кінцівку. Ознаки кульгавості присутні не постійно і проявляються час від часу.
У сукотної самки, зараженої мікоплазмою, часто реєструються викидні та мертвонародженість.
До загальних ознак мікоплазмової інфекції належать: підвищення температури тіла, апатичність, млявість, поганий апетит. У разі ураження шлунково-кишкового тракту спостерігаються блювота і пронос у собак.
Наслідки мікоплазмозу у собак
У разі запалення кон’юнктиви на тлі мікоплазмозу у собак може виникнути вторинна інфекція. Так, наприклад, при запаленні кон’юнктиви нерідко розвивається гнійний кон’юнктивіт. Офтальмологічне захворювання за відсутності грамотного лікування стає причиною порушення зору (катаракта, глаукома).
Тривалий перебіг мікоплазмових бронхітів небезпечний розвитком обструктивної хвороби легень.
У разі ураження ротової порожнини можуть розвиватися хронічні гінгівіти, які своєю чергою стають причиною пародонту. На тлі стоматологічного захворювання відбувається повна або часткова втрата зубів.
Мікоплазмові артрити призводять до руйнування хрящової тканини та утворення ерозій на поверхні суглоба.
У хворих сук при мікоплазмозі часто відбувається переривання вагітності, народження недорозвинених цуценят. Також спостерігається висока смертність потомства в перші дні після народження.
Гемотрофічний мікоплазмоз, що вражає клітини крові, стає причиною розвитку анемії у тварин.
Діагностичні заходи
Найефективніший метод діагностики мікоплазмової інфекції — ПЛР (полімерна ланцюгова реакція). При підозрі на мікоплазмоз у собаки беруть мазки з кон’юнктиви, роблять змиви зі слизових статевих, дихальних органів (залежно від локалізації інфекційного процесу). Ефективність ПЛР багато в чому визначається якістю забору дослідницького матеріалу.
Інформативними також можуть бути аналіз сечі за наявності патогенів у сечостатевій системі. Забір крові проводиться для визначення чутливості мікоплазм до тих чи інших антибіотиків.
Схема лікування мікоплазмозу
Єдиної схеми лікування мікоплазмової інфекції не існує. Підхід до терапії залежить від ступеня тяжкості хвороби та місця локалізації мембранних паразитів. В обов’язковому порядку собаці призначають:
- антибіотики;
- гепатопротектори;
- імуномодулятори;
- пробіотики або пребіотики.
Мікоплазми чутливі до антибактеріальних медикаментів групи амфеніколів (Левоміцетин), макролідів (еритроміцин), тетрациклінів (Доксициклін), фторхіонолонів (Офлоксацин, Енроксил).
Оскільки патогенні мікроорганізми швидко виробляють резистентність (стійкість) до антибіотиків, призначають комбінацію препаратів.
Тривалість лікування може варіюватися від 1 до 3 тижнів і строго / виключно / суворо визначається лікарем. Після закінчення курсу антибіотиків собаці призначають повторні аналізи.
У разі інфекцій дихальної, сечостатевої, травної системи, що виникли на тлі мікоплазмозу, може бути призначений комбінований препарат з антибактеріальною і противірусною дією Рибафлокс або аналогічний препарат.
Тривалий прийом антибіотиків негативно позначається на роботі печінки. Тому собакам показано застосування гепатопротекторів (Гепатовет, Гепатіалє Форте (Hepatiale Forte), Гепатолюкс та ін.). Тривалість застосування від 3 до 5 тижнів.
Лікування мікоплазмозу, що протікає одночасно з вірусною інфекцією, зводиться до додаткового прийому противірусних препаратів (Рибавірин, Максидин 0,4).
З імуномодуляторів тварині можуть бути призначені Гамавіт, Азоксівет, Фоспреніл тощо.
Пробіотики для собак (Фортіфлора, Лактоферон, Ветом 1) призначають після антибактеріальної терапії для відновлення мікробіоти кишківника і стимуляції імунітету.
У разі розвитку мікоплазменного кон’юнктивіту показані медикаменти місцевої дії у вигляді крапель (Ципровет) або мазі (Тетрациклін 1%).

У разі циститу на тлі мікоплазмозу, крім антибіотиків, додатково показана фітотерапія, що має протизапальний і сечогінний ефект (Стоп-Цистит, Котервін, Цистон).
У разі вагінітів і баланопоститів призначають промивання антисептичними розчинами (Мірамістин, Хлоргексидин) і нанесення місцевих антибактеріальних мазей (тетрациклінової, левоміцетинової та ін.).
Застосування стероїдних мазей при урогенітальних захворюваннях на тлі мікоплазмозу протипоказане.
У разі розвитку мікоплазмозних артритів необхідний прийом протизапальних препаратів зі знеболювальним ефектом (суспензія або таблетки Синулокс для собак, а також його аналоги) і хондропротектори (таблетки Артроглікан, Канвіт Хондро, Страйд Плюс).
Хвору тварину обов’язково ізолюють від інших домашніх улюбленців.
Імунітет до мікоплазмозу у собак, як правило, нетривалий. Ослаблена тварина може заразитися повторно. Причиною рецидиву також є видова різноманітність збудника.
Профілактика мікоплазмозу в собак
Вакцин проти мікоплазмозу не розроблено, тому для попередження інфекції дотримуються неспецифічних заходів профілактики:
- забезпечують повноцінне годування та догляд;
- своєчасно лікують інші патології;
- обмежують контакт із бездомними тваринами;
- забороняють собаці підбирати їжу на вулиці;
- проводять планові обробки від паразитів;
- своєчасно вакцинують тварину.
Під час в’язки собак бажано здати суці (собаці) та псу аналіз на мікоплазмоз.
Профілактичні огляди у ветеринара, підтримання фізичної активності також належать до заходів профілактики інфекції.
Часті рецидиви кон’юнктивіту є приводом здачі аналізу на мікоплазми.
Мікоплазмоз собак — підступне захворювання, що має стерту клінічну картину. Розпізнати інфекцію на ранніх етапах практично неможливо. Мікоплазми активізуються тільки в ослабленому організмі тварини. Для запобігання розвитку хвороби необхідно зміцнювати імунітет вихованця та проводити регулярні огляди у ветеринарного фахівця.
Поведінкові особливості тварин у 2026 — досвід експертів.












⚠️ Усі висновки на нашому порталі ми пропонуємо вам прочитати і взяти до відома на ваш розсуд. Не займайтеся самолікуванням! У наших статтях ми збираємо останні наукові дані та думки авторитетних експертів у галузі здоров'я. Але пам'ятайте: поставити діагноз та призначити лікування може лише лікар.
Портал призначений для користувачів старше 13 років. Деякі матеріали можуть не підходити для дітей молодше 16 років. Ми не збираємо персональні дані у дітей молодше 13 років без згоди батьків.У нас є невелике прохання. Ми намагаємося створювати якісний контент, який допомагає піклуватися про домашніх вихованців, і робимо його доступним безоплатно для всіх, тому що віримо, що кожен заслуговує на точну і корисну інформацію.
Рекламні доходи покривають лише невелику частину наших витрат, і ми хочемо продовжувати надавати контент без необхідності збільшувати кількість реклами. Якщо наші матеріали виявилися вам корисними, будь ласка, підтримайте нас. Це займе всього хвилину, але ваша підтримка допоможе нам скоротити залежність від реклами і створювати ще більше корисних статей. Дякуємо!


